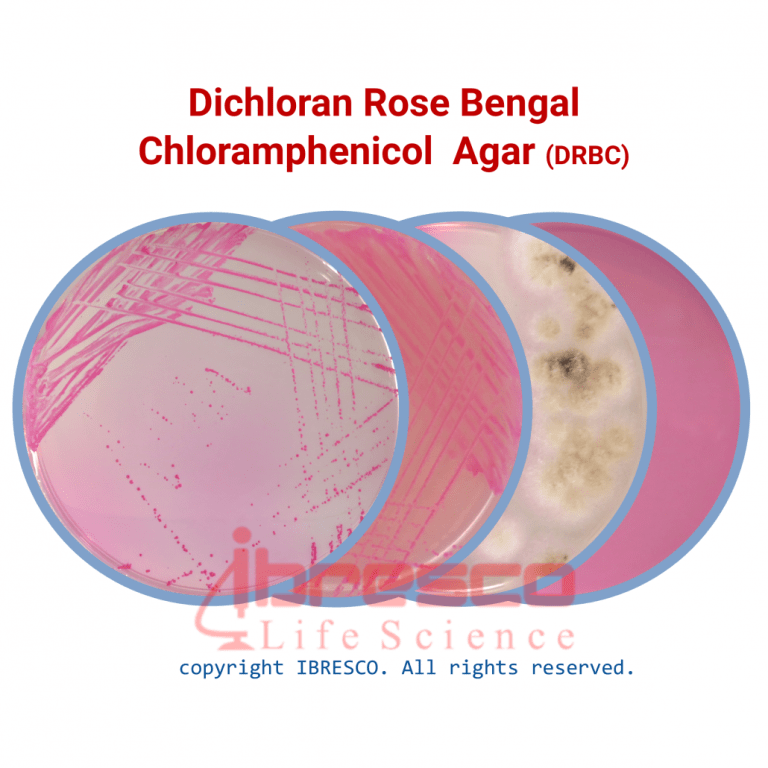

Dichloran Rose Bengal Chloramphenicol (DRBC) Agar | دیکلران رز بنگال کلرامفنیکل آگار ایبرسکو
Dichloran Rose Bengal Chloramphenicol (DRBC) Agar | دیکلران رز بنگال کلرامفنیکل آگار ایبرسکو
دانلود سرتیفیکیت Dichloran Rose Bengal Chloramphenicol (DRBC) Agar | دیکلران رز بنگال کلرامفنیکل آگار ایبرسکو
کاربرد: محیط انتخابی برای شمارش کپک و مخمر فاسدکننده مواد غذایی
استاندارد: BAM, APHA, ISO 21527-1, ISIRI 1899-1 (استاندارد ملی ایران)
- قوطی محیط کشت DRBC آگار را به خوبی تکان دهید. مقدار ۳۱/۶ گرم از محیط را در ۱ لیتر آب مقطر حل کنید.
- محلول را بجوشانید تا پودر محیط کاملا در آب حل شود.
- در دمای ۱۲۱ درجه سانتی گراد به مدت ۱۵ دقیقه اتوکلاو کنید.
- پس از اتوکلاو، محیط را تا دمای ۵۰ درجه سانتی گراد خنک کنید و سپس در پلیت پخش کنید.
شرایط نگهداری
پودر محیط داخل قوطی کاملا در بسته و در دمای زیر ۳۰ درجه سانتی گراد و محیط آماده در دمای ۸-۲ درجه سانتی گراد نگهداری شود. بهترین زمان استفاده تا قبل از تاریخ انقضای درج شده بر روی برچسب محصول است.
ویژگی ها
- ضمانت اصالت کالا
- ارسال سریع کالا
- مشاوره کاهش هزینه ها
- خرید بهترین برندهای خارجی و داخلی با قیمت مناسب
- پشتیبانی 24 ساعته
- امکان سفارش در حجم و اندازه مورد نیاز بسیاری از محصولات
- 8161 351 935 98+
Dichloran Rose Bengal Chloramphenicol (DRBC) Agar | دیکلران رز بنگال کلرامفنیکل آگار ایبرسکو
دانلود سرتیفیکیت Dichloran Rose Bengal Chloramphenicol (DRBC) Agar | دیکلران رز بنگال کلرامفنیکل آگار ایبرسکو
کاربرد: محیط انتخابی برای شمارش کپک و مخمر فاسدکننده مواد غذایی
استاندارد: BAM, APHA, ISO 21527-1, ISIRI 1899-1 (استاندارد ملی ایران)
- قوطی محیط کشت DRBC آگار را به خوبی تکان دهید. مقدار ۳۱/۶ گرم از محیط را در ۱ لیتر آب مقطر حل کنید.
- محلول را بجوشانید تا پودر محیط کاملا در آب حل شود.
- در دمای ۱۲۱ درجه سانتی گراد به مدت ۱۵ دقیقه اتوکلاو کنید.
- پس از اتوکلاو، محیط را تا دمای ۵۰ درجه سانتی گراد خنک کنید و سپس در پلیت پخش کنید.
شرایط نگهداری
پودر محیط داخل قوطی کاملا در بسته و در دمای زیر ۳۰ درجه سانتی گراد و محیط آماده در دمای ۸-۲ درجه سانتی گراد نگهداری شود. بهترین زمان استفاده تا قبل از تاریخ انقضای درج شده بر روی برچسب محصول است.
فرآیند آزمایش
- نمونه غذایی مورد نظر را مطابق پروتکل مربوطه رقیق کرده و از آن رقت سریالی تهیه کنید.
- مقدار ۰/۱ از نمونه را بر روی پلیت تلقیح کرده و کاملا در سطح آن پخش کنید.
- پلیتهای تلقیح شده را تا ۵ روز در دمای ۲۵ درجه سانتی گراد گرماگذاری کنید.
نتیجه و تفسیر
- رشد بر روی پلیت را پس از ۳، ۴ و ۵ روز گرماگذاری بررسی کنید.
- کلنی های مخمر بر روی این محیط کشت، به دلیل جذب رز بنگال، به رنگ صورتی درمی آیند.
- تعداد کلنی ها را در ۱ گرم از ماده غذایی محاسبه کنید.
نکته
- محیط کشت DRBC دارای pH پایینی است که این مساله می تواند احتمال عدم رشد مخمرها در حضور رز بنگال را افزایش دهد. به همین دلیل، در صورتی که نیاز است علاوه بر کپک، مخمرها نیز شمارش شوند، بهتر است همزمان از محیط کشت رز بنگال کلرامفنیکل آگار (شماره کاتالوگ i23159) نیز برای کشت نمونه استفاده شود.
- به دلیل ویژگی های اختصاصی محیط کشت DRBC Agar، این امکان وجود دارد که برخی از سویه های کپک یا مخمر بر روی این محیط کشت رشد نکنند و یا رشد خوبی نداشته باشند. همچنین، ممکن است از رشد برخی باکتری ها در این محیط کاملا یا به طور نسبی جلوگیری نشود.
- توجه داشته باشید که محیط کشت DRBC Agar در معرض نور قرار نگیرد، چرا که رز بنگال موجود در ترکیب این محیط در مقابل نور اکسیده می شود و تولید مواد سمی ای می کند که برای رشد کپک و مخمر مضر است.
محصولات مرتبط
| شماره کاتالوگ | بسته بندی | محصول |
|---|---|---|
|
i23159
|
قوطی ۱۰۰ گرمی و ۵۰۰ گرمی
|
Rose Bengal Chloramphenicol Agar
|
کنترل کیفی
- ظاهر محیط دهیدراته: صورتی رنگ، پودری و یکنواخت
- ظاهر محیط آماده: صورتی رنگ
- نتیجه کشت باکتری، پس از گرماگذاری در دمای ۲۵ درجه سانتی گراد به مدت ۵ روز
| رشد | ATCC | سوش استاندارد |
|---|---|---|
|
خوب
|
9763
|
Saccharomyces cerevisiae
|
|
خوب
|
10231
|
Candida albicans
|
|
خوب
|
16404
|
Aspergillus niger
|
|
منفی
|
6633
|
Bacillus subtilus
|
|
منفی
|
25922
|
Escherichia coli
|
| گرم بر لیتر | ترکیبات |
|---|---|
|
5.0
|
Peptone
|
|
10.0
|
Glucose
|
|
1.0
|
Potassium Dihydrogen Phosphate
|
|
0.002
|
Dichloran
|
|
0.5
|
Magnesium Sulfate
|
|
0.025
|
Rose Bengal
|
|
0.1
|
Chloramphenicol
|
|
15.0
|
Agar
|
|
0.2 ± 5.6
|
Final pH
|
محصولات پیشنهادی
دیدگاهها
حذف فیلترهاهیچ دیدگاهی برای این محصول نوشته نشده است.